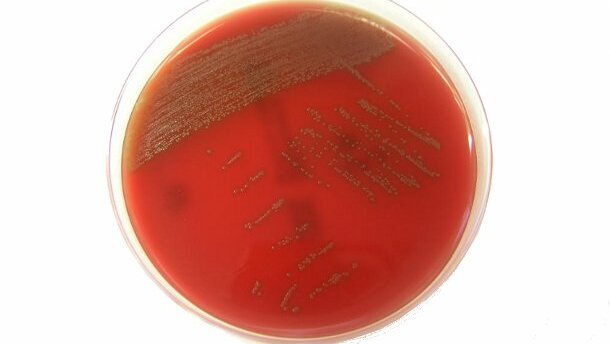
Une bactérie sur les muqueuses buccales pourrait provoquer des maladies graves si elle passe dans le sang

ZURICH, Suisse : La bactérie, identifiée par des chercheurs de l’Institut de Microbiologie Médicale de Zurich, a été nommée Streptococcus tigurinus d’après la région de Zurich où elle a été découverte.
Streptococcus tigurinus a été isolé à partir de sang de patients souffrant d'endocardite, de méningite et spondylodiscite (inflammation de la colonne vertébrale). Elle a une étroite ressemblance avec d'autres souches de Streptocoques présentent dans la bouche. Cette ressemblance suggère que la bactérie existait déjà mais n’avait jusqu’à présent pas été identifiée.
Son identification récente est cliniquement importante, affirme le Dr Andrea Zbinden qui a dirigé l'étude. "Des recherches plus approfondies doivent maintenant être faites pour comprendre les stratégies qu’elle utilise pour provoquer des maladies. Cela permettra aux patients infectés d’être traités plus rapidement et avec le bon médicament. Cette bactérie semble avoir un potentiel naturel pour provoquer des maladies graves et il est donc important que les cliniciens et les microbiologistes soient au courant de son existence" explique le Dr Zbinden dans l’International Journal of Systematic and Evolutionary Microbiology, publié le 22 février 2012.
COPENHAGUE, Danemark : Des recherches récentes menées par l'Université de Copenhague et l'hôpital de Næstved au Danemark ont démontré que la ...
LIVERPOOL/PLYMOUTH, Royaume-Uni : Le lien entre la santé bucco-dentaire et les maladies chroniques est de plus en plus étayé par des preuves ...
LONDRES, Royaume-Uni : Les bactéries normales qui vivent dans notre bouche fournissent le catalyseur pour le développement de la maladie ...
Nous allons aborder la place de la phytothérapie dans le traitement des lésions buccales, dont notamment les aphtes, les mycoses buccales, l’herpès. Le...
MONTRÉAL, Canada : Des chercheurs de l’université de Montréal, Canada, ont découvert qu’une protéine, la phosphoprotéine sécrétoire ...
TEL AVIV, Israël : Des scientifiques de Tel Aviv ont réussi à recueillir les cellules de la muqueuse buccale et à les transformer ...
RUGBY, Royaume-Uni / NEW HAVEN, États-Unis : Des chercheurs de l'Ecole de Médecine de l'Université de Yale ont trouvé que ...
LUND, Suède / AMSTERDAM, Pays-Bas : Une étude suédoise a révélé que les patients dialysés qui avaient une ...
Les chercheurs ont identifié le gène qui contrôle la production finale de l'émail dentaire, une avancée significative qui ...
BARI, Italie: Un nombre croissant de produits apparaissent sur le marché, visant à remplacer les dentifrices et les bains de bouche contenant des ...
Webinaire en direct
mar. le 23 juin 2026
à 2h00 (CET) Paris
Webinaire en direct
mar. le 23 juin 2026
à 19h00 (CET) Paris
Webinaire en direct
mar. le 23 juin 2026
à 21h00 (CET) Paris
Webinaire en direct
mer. le 24 juin 2026
à 14h00 (CET) Paris
Webinaire en direct
mer. le 24 juin 2026
à 17h00 (CET) Paris
Webinaire en direct
mer. le 24 juin 2026
à 18h30 (CET) Paris
Dr. med. dent. Britta Hahn
Webinaire en direct
jeu. le 25 juin 2026
à 20h00 (CET) Paris
Dr. Hatem Algraffee, Cat Edney



 Autriche / Österreich
Autriche / Österreich
 Bosnie Herzégovine / Босна и Херцеговина
Bosnie Herzégovine / Босна и Херцеговина
 Bulgarie / България
Bulgarie / България
 Croatie / Hrvatska
Croatie / Hrvatska
 République tchèque et Slovaquie / Česká republika & Slovensko
République tchèque et Slovaquie / Česká republika & Slovensko
 France / France
France / France
 Allemagne / Deutschland
Allemagne / Deutschland
 Grèce / ΕΛΛΑΔΑ
Grèce / ΕΛΛΑΔΑ
 Hongrie / Hungary
Hongrie / Hungary
 Italie / Italia
Italie / Italia
 Pays-Bas / Nederland
Pays-Bas / Nederland
 Nordique / Nordic
Nordique / Nordic
 Pologne / Polska
Pologne / Polska
 Portugal / Portugal
Portugal / Portugal
 Roumanie & Moldavie / România & Moldova
Roumanie & Moldavie / România & Moldova
 Slovénie / Slovenija
Slovénie / Slovenija
 Serbie et Monténégro / Србија и Црна Гора
Serbie et Monténégro / Србија и Црна Гора
 Espagne / España
Espagne / España
 Suisse / Schweiz
Suisse / Schweiz
 Turquie / Türkiye
Turquie / Türkiye
 Royaume-Uni et Irlande / UK & Ireland
Royaume-Uni et Irlande / UK & Ireland
 International / International
International / International
 Brésil / Brasil
Brésil / Brasil
 Canada / Canada
Canada / Canada
 Amérique latine / Latinoamérica
Amérique latine / Latinoamérica
 États-Unis / USA
États-Unis / USA
 Chine / 中国
Chine / 中国
 Inde / भारत गणराज्य
Inde / भारत गणराज्य
 Pakistan / Pākistān
Pakistan / Pākistān
 Vietnam / Việt Nam
Vietnam / Việt Nam
 ANASE / ASEAN
ANASE / ASEAN
 Israël / מְדִינַת יִשְׂרָאֵל
Israël / מְדִינַת יִשְׂרָאֵל
 Algérie, Maroc et Tunisie / الجزائر والمغرب وتونس
Algérie, Maroc et Tunisie / الجزائر والمغرب وتونس
 Moyen-Orient / Middle East
Moyen-Orient / Middle East

To post a reply please login or register